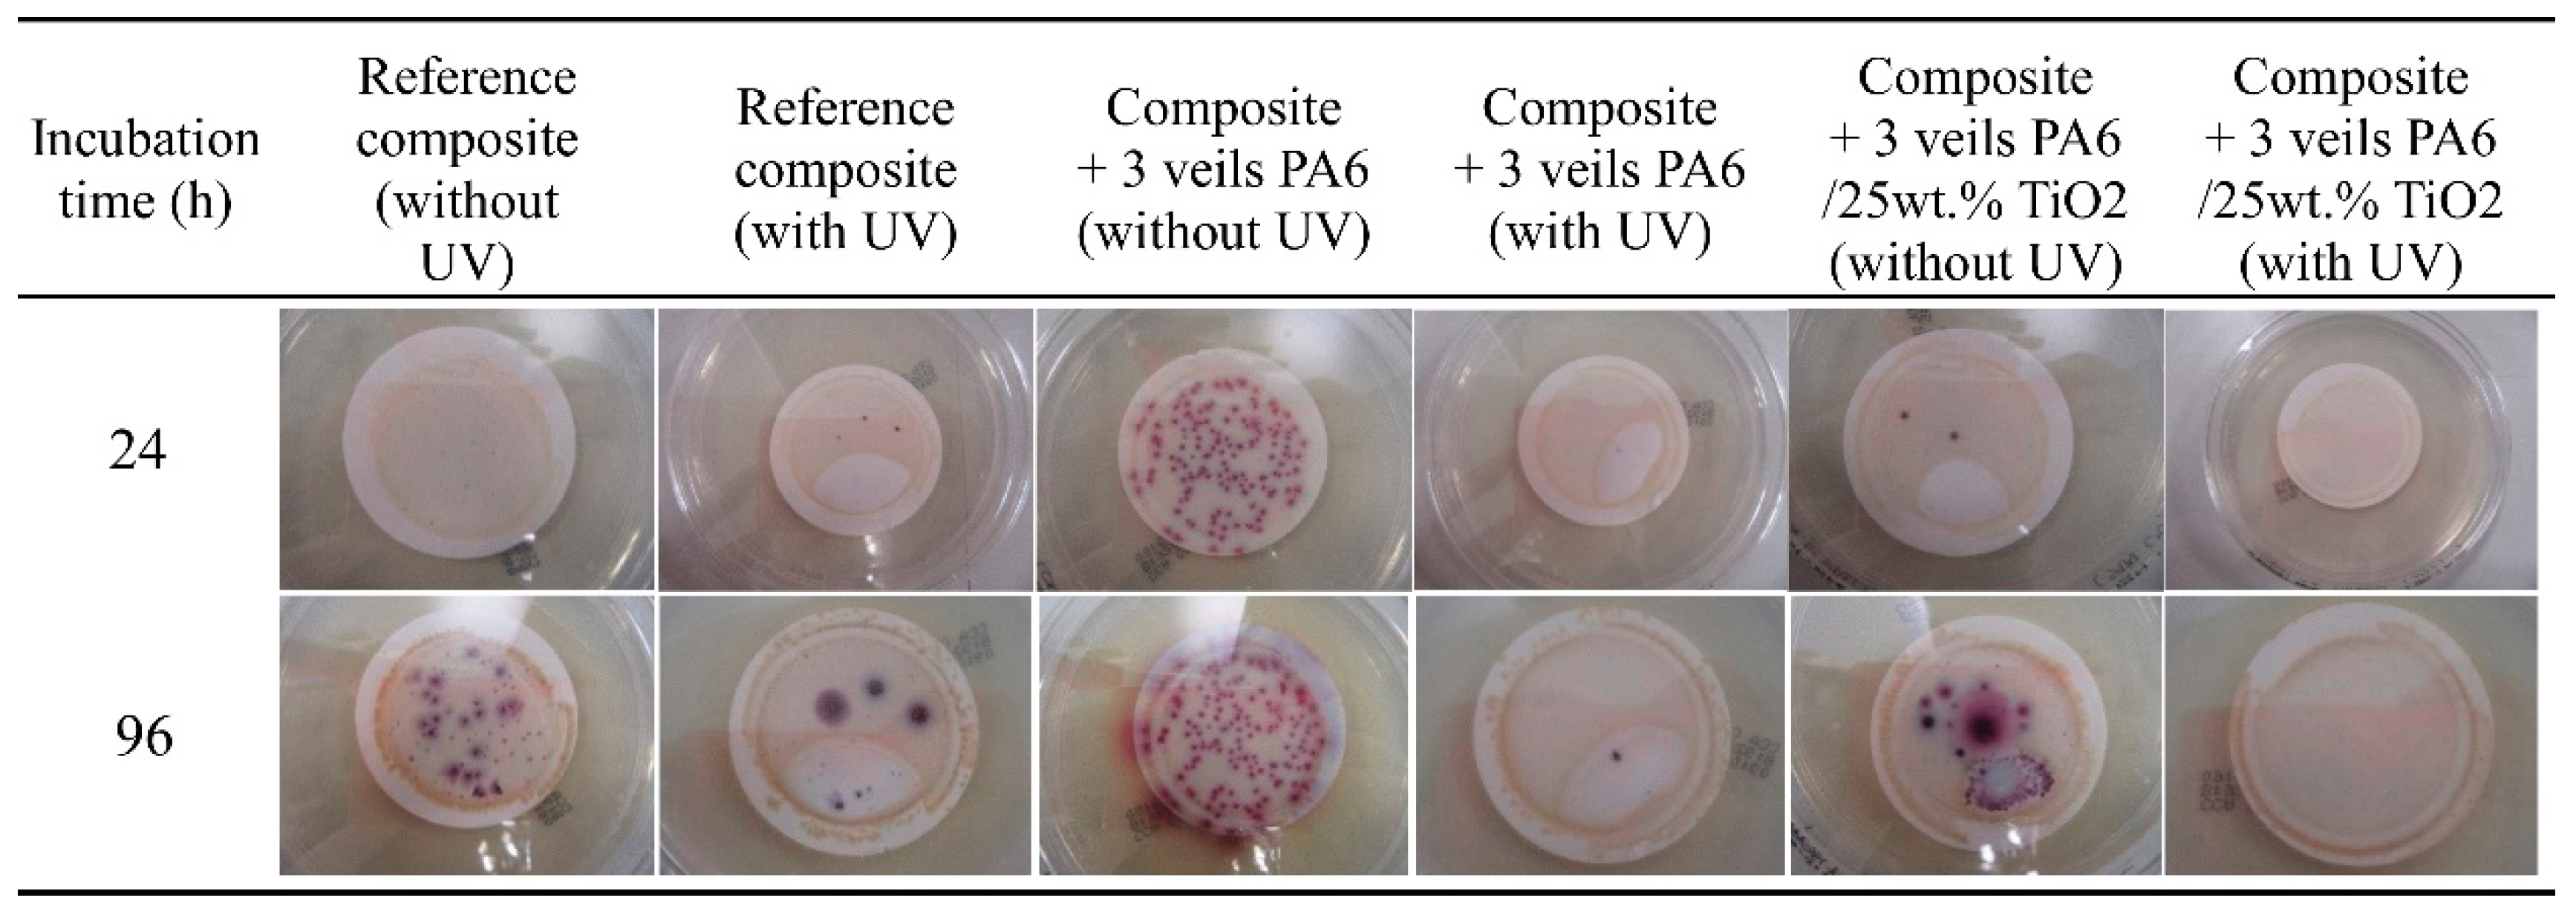
Polymers 11 01524 g007 Polymers 11 01524 g007

Novel Antibacterial and Toughened Carbon-Fibre/Epoxy Composites by the Incorporation of TiO2 Nanoparticles Modified Electrospun Nanofibre Veils
Abstract
1. Introduction
2. Materials and Methods
2.1. Materials
2.2. Sample Preparation
2.3. Characterization Techniques
3. Results and Discussion
3.1. Mechanical Characterization
3.2. Antibacterial Behavior Characterization
4. Conclusions
Supplementary Materials
Author Contributions
Funding
Acknowledgments
Conflicts of Interest
References
- Peters, S.T. Handbook of Composites, 2nd ed.; Chapman and Hall: London, UK, 1998. [Google Scholar]
- Beylergil, B.; Tanoglu, M.; Aktas, E. Enhancement of interlaminar fracture toughness of carbon fibre–epoxy composites using polyamide-6,6 electrospun nanofibers. J. Appl. Polym. Sci. 2017, 134, 45244. [Google Scholar] [CrossRef]
- Duan, G.; Fang, H.; Huang, C.; Jiang, S.; Hou, H. Microstructures and mechanical properties of aligned electrospun carbon nanofibers from binary composites of polyacrylonitrile and polyamic acid. J. Mater. Sci. 2018, 53, 15096–15106. [Google Scholar] [CrossRef]
- Zhou, S.; Zhou, G.; Jiang, S.; Fan, P.; Hou, H. Flexible and refractory tantalum carbide-carbon electrospun nanofibers with high modulus and electric conductivity. Mater. Lett. 2017, 200, 97–100. [Google Scholar] [CrossRef]
- Kuwata, M.; Hogg, P.J. Interlaminar Toughness of Interleaved CFRP Using Non-Woven Veils: Part 1. Mode-I Testing. Compos. Part A Appl. Sci. Manuf. 2011, 42, 1551–1559. [Google Scholar] [CrossRef]
- Jiang, S.; Chen, Y.; Duan, G.; Mei, C.; Greiner, A.; Agarwal, S. Electrospun nanofiber reinforced composites: A review. Polym. Chem. 2018, 9, 2685–2720. [Google Scholar] [CrossRef]
- Gomez-del Río, T.; Salazar, A.; Pearson, R.A.; Rodríguez, J. Fracture behaviour of epoxy nanocomposites modified with triblock copolymers and carbon nanotubes. Compos. Part B Eng. 2016, 87, 343–349. [Google Scholar] [CrossRef]
- Radue, M.S.; Odegard, G.M. Multiscale modeling of carbon fiber/carbon nanotube/epoxy hybrid composites: Comparison of epoxy matrices. Compos. Sci. Technol. 2018, 166, 20–26. [Google Scholar] [CrossRef]
- Rafiq, A.; Merah, N.; Boukhili, R.; Al-Qadhi, M. Impact resistance of hybrid glass fiber reinforced epoxy/nanoclay composite. Polym. Test. 2017, 57, 1–11. [Google Scholar] [CrossRef]
- Bahrami, A.; Cordenier, F.; Van Velthem, P.; Ballout, W.; Pardoen, T.; Nysten, B.; Bailly, C. Synergistic local toughening of high performance epoxy-matrix composites using blended block copolymer-thermoplastic thin films. Compos. Part A Appl. Sci. Manuf. 2016, 91, 398–405. [Google Scholar] [CrossRef]
- Xu, F.; Du, X.S.; Liu, H.Y.; Guo, W.G.; Mai, Y.W. Temperature effect on nano-rubber toughening in epoxy and epoxy/carbon fiber laminated composites. Compos. Part B Eng. 2016, 95, 423–432. [Google Scholar] [CrossRef]
- Coleman, J.N.N. Small but strong: A review of the mechanical properties of carbon nanotube-polymer composites. Carbon 2006, 44, 1624–1652. [Google Scholar] [CrossRef]
- Tsu-Wei, C. An assessment of the science and technology of carbon nanotube-based fibers and composites. Compos. Sci. Technol. 2009, 71, 1–19. [Google Scholar]
- Qian, H.; Greenhalgh, E.S.; Shaffer, M.S.P.; Bismarck, A. Carbon nanotube based hierarchical composites: A review. J. Mater. Chem. 2010, 20, 4751–4762. [Google Scholar] [CrossRef]
- Pieters, R.; Miltner, H.E.; Van Assche, G.; Van Mele, B. Kinetics of temperature-induced and reaction-induced phase separation studied by modulated temperature DSC. Macromol. Symp. 2006, 233, 36–41. [Google Scholar] [CrossRef]
- Dzenis, Y.A.; Reneker, D.H. Delamination Resistant Composites Prepared by Small Diameter Fiber Reinforcement at Ply Interfaces. U.S. Patent 6,265,333, 24 July 2001. [Google Scholar]
- Kim, J.; Reneker, D.H. Mechanical properties of composites using ultrafine electrospun fibers. Polym. Compos. 1999, 20, 124–131. [Google Scholar] [CrossRef]
- Chen, Y.; Sui, L.; Fanga, H.; Ding, C.H.; Li, Z.; Jiang, S.; Hou, H. Superior mechanical enhancement of epoxy composites reinforced by polyimide nanofibers via a vacuum-assisted hot-pressing. Compos. Sci. Technol. 2019, 174, 20–26. [Google Scholar] [CrossRef]
- Duan, G.; Liu, S.; Jiang, S.; Hou, H. High-performance polyamide-imide films and electrospun aligned nanofibers from an amidecontaining diamine. J. Mater. Sci. 2019, 54, 6719–6727. [Google Scholar] [CrossRef]
- Xu, H.; Jiang, S.; Ding, C.H.; Zhu, Y.; Li, J.; Hou, H. High strength and high breaking load of single electrospun polyimide microfiber from water soluble precursor. Mater. Lett. 2017, 201, 82–84. [Google Scholar] [CrossRef]
- Ding, C.H.; Fang, H.; Duan, G.; Zou, Y.; Chen, S.; Hou, H. Investigating the draw ratio and velocity of an electrically charged liquid jet during electrospinning. RSC Adv. 2019, 9, 13608–13613. [Google Scholar] [CrossRef]
- Yang, H.; Jiang, S.; Fang, H.; Hu, X.; Duan, G.; Hou, H. Molecular orientation in aligned electrospun polyimide nanofibers by polarized FT-IR spectroscopy. Spectrochim. Acta A 2018, 200, 339–344. [Google Scholar] [CrossRef]
- Jian, S.; Zhu, J.; Jiang, S.; Chen, S.; Fang, H.; Song, Y.; Duan, G.; Zhang, Y.; Hou, H. Nanofibers with diameter below one nanometer from electrospinning. RSC Adv. 2018, 8, 4794–4802. [Google Scholar] [CrossRef]
- Hou, H.; Xu, W.; Ding, Y. The recent progress on high-performance polymer nanofibers by electrospinning. J. Jiangxi Norm. Univ. (Nat. Sci.) 2018, 42, 551–564. [Google Scholar]
- Zheng, N.; Huang, Y.; Liu, H.Y.; Gao, J.; Mai, Y.W. Improvement of interlaminar fracture toughness in carbon fiber/epoxy composites with carbon nanotubes/polysulfone interleaves. Compos. Sci. Technol. 2017, 140, 8–15. [Google Scholar] [CrossRef]
- Beckermann, G.W. Nanofiber interleaving veils for improving the performance of composite laminates. Reinf. Plast. 2017, 61, 289–293. [Google Scholar] [CrossRef]
- Brugo, T.; Palazzetti, R. The effect of thickness of Nylon 6,6 nanofibrous mat on Modes I-II fracture mechanics of UD and woven composite laminates. Compos. Struct. 2016, 154, 172–178. [Google Scholar] [CrossRef]
- Monteserín, C.; Blanco, M.; Murillo, N.; Pérez-Márquez, A.; Maudes, J.; Gayoso, J.; Laza, J.M.; Aranzabe, E.; Vilas, J.L. Effect of Different Types of Electrospun Polyamide 6 Nanofibres on the Mechanical Properties of Carbon Fibre/Epoxy Composites. Polymers 2018, 10, 1190. [Google Scholar] [CrossRef] [PubMed]
- Ignatova, M.; Rashkov, I.; Manolova, N. Drug-loaded electrospun materials in wound-dressing applications and in local cancer treatment. Expert Opin. Drug Deliv. 2013, 10, 469–483. [Google Scholar] [CrossRef]
- Zhong, W.; Xing, M.M.Q.; Maibach, H.I. Nanofibrous materials for wound care. Cutan. Ocul. Toxicol. 2010, 29, 143–152. [Google Scholar] [CrossRef]
- Zahedi, P.; Rezaeian, I.; Ranaei-Siadat, S.O.; Jafari, S.H.; Supaphol, P. A review on wound dressings with an emphasis on electrospun nanofibrous polymeric bandages. Polym. Adv. Technol. 2010, 21, 77–95. [Google Scholar] [CrossRef]
- Liu, M.; Duan, X.P.; Li, Y.M.; Yang, D.P.; Long, Y.Z. Electrospun nanofibers for wound healing. Mater. Sci. Technol. 2017, 76, 1413–1423. [Google Scholar] [CrossRef]
- Pant, H.R.; Pant, B.; Pokharel, P.; Kim, H.J.; Tijing, L.D.; Park, C.H.; Lee, D.S.; Kim, H.Y.; Kim, C.S. Photocatalytic TiO2-RGO/nylon-6 spider-wave-like nano-nets via electrospinning and hydrothermal treatment. J. Membr. Sci. 2013, 429, 225–234. [Google Scholar] [CrossRef]
- Shalumon, K.; Anulekha, K.; Nair, S.V.; Nair, S.; Chennazhi, K.; Jayakumar, R. Sodium alginate/poly (vinyl alcohol)/nano ZnO composite nanofibers for antibacterial wound dressings. Int. J. Biol. Macromol. 2011, 49, 247–254. [Google Scholar] [CrossRef] [PubMed]
- Lee, K.; Lee, S. Multifunctionality of poly (vinyl alcohol) nanofiber webs containing titanium dioxide. J. Appl. Polym. Sci. 2012, 124, 4038–4046. [Google Scholar] [CrossRef]
- Choi, J.; SomMoon, D.; Jang, J.U.; Yin, W.B.; Lee, B.; Lee, K.J. Synthesis of Highly Functionalized Thermoplastic Polyurethanes and Their Potential Applications. Polymer 2017, 116, 287–294. [Google Scholar] [CrossRef]
- Han, K.Q.; Yu, M.H. Study of the preparation and properties of UV-blocking fabrics of a PET/TiO2 nanocomposite prepared by in situ polycondensation. J. Appl. Polym. Sci. 2006, 100, 1588–1593. [Google Scholar] [CrossRef]
- Haider, A.; Kwak, S.; Gupta, K.C.; Kang, I.K. Antibacterial activity and cytocompatibility of PLGA/CuO hybrid nanofiber scaffolds prepared by electrospinning. J. Nanomater. 2015, 2015, 1–10. [Google Scholar] [CrossRef]
- Quirós, J.; Boltes, K.; Aguado, S.; de Villoria, R.G.; Vilatela, J.J.; Rosal, R. Antimicrobial metal–organic frameworks incorporated into electrospun fibers. Chem. Eng. J. 2015, 262, 189–197. [Google Scholar] [CrossRef]
- Amna, T.; Hassan, M.S.; Barakat, N.A.; Pandeya, D.R.; Hong, S.T.; Khil, M.S.; Kim, H.Y. Antibacterial activity and interaction mechanism of electrospun zinc-doped titania nanofibers. Appl. Microbiol. Biotechnol. 2012, 93, 743–751. [Google Scholar] [CrossRef]
- Hwang, S.H.; Song, J.; Jung, Y.; Kweon, O.Y.; Song, H.; Jang, J. Electrospun ZnO/TiO2 composite nanofibers as a bactericidal agent. Chem. Commun. 2011, 47, 9164–9166. [Google Scholar] [CrossRef]
- Ye, C.X.; Li, H.Q.; Cai, A.; Gao, Q.Z.; Zeng, X.R. Preparation and Characterization of Organic Nano-Titanium Dioxide/Acrylate Composite Emulsions by in-situ Emulsion Polymerization. J. Macromol. Sci. A Pure Appl. Chem. 2011, 48, 309–314. [Google Scholar] [CrossRef]
- Yoshida, M.; Lal, M.; Kumar, N.D.; Prasad, P.N. TiO2 nano-particle-dispersed polyimide composite optical waveguide materials through reverse micelles. J. Mater. Sci. 1997, 32, 4047–4051. [Google Scholar] [CrossRef]
- Barnard, A.S.; Curtiss, L.A. Prediction of TiO2 Nanoparticle Phase and Shape Transitions Controlled by Surface Chemistry. Nano Lett. 2005, 5, 1261–1266. [Google Scholar] [CrossRef] [PubMed]
- Sundarrajan, S.; Ramakrishna, S. Fabrication of nanocomposite membranes from nanofibers and nanoparticles for protection against chemical warfare stimulants. J. Mater. Sci. 2007, 42, 8400–8407. [Google Scholar] [CrossRef]
- Sundarrajan, S.; Luck, K.; Huat, S.; Ramakrishna, S. Electrospun nanofibers for air filtration applications. Procedia Eng. 2014, 75, 59–163. [Google Scholar] [CrossRef]
- Danni, N.; Sasikumar, T.; Fazil, A.A. Mechanical properties of electrospun CNF/PVA nanofiber mats as reinforcement in polymer matrix composites. Int. J. Appl. Chem. 2016, 12, 107–119. [Google Scholar]
- Li, B.; Yuan, H.; Zhang, Y. Transparent PMMA-based nanocomposite using electrospun graphene-incorporated PA-6 nanofibers as the reinforcement. Compos. Sci. Technol. 2013, 89, 134–141. [Google Scholar] [CrossRef]
- Neppalli, R.; Causin, V.; Benetti, E.M.; Ray, S.S.; Esposito, A.; Wanjale, S.; Birajdar, M.; Saiter, J.M.; Marigo, A. Polystyrene/TiO2 composite electrospun fibers as fillers for poly(butylene succinate-co-adipate): Structure, morpholog and properties. Eur. Polym. J. 2014, 50, 78–86. [Google Scholar] [CrossRef]
- Marega, C.; Marigo, A. Effect of electrospun fibers of polyhydroxybutyrate filled with different organoclays on morphology, biodegradation, and thermal stability of poly(ε-caprolattone). J. Appl. Polym. Sci. 2015, 132, 42342–42354. [Google Scholar] [CrossRef]
- Chang, Z.J. Development of a polyurethane nanocomposite reinforced with carbon nanotube composite nanofibers. Mater. Sci. Forum 2011, 688, 41–44. [Google Scholar] [CrossRef]
- Liu, L.; Zhou, Y.; Pan, S. Experimental and analysis of the mechanical behaviors of multi-walled nanotubes/polyurethane nanoweb-reinforced epoxy composites. J. Reinf. Plast. Compos. 2013, 32, 823–834. [Google Scholar] [CrossRef]
- Blanco, M.; Monteserín, C.; Angulo, A.; Pérez-Márquez, A.; Maudes, J.; Murillo, N.; Aranzabe, E.; Ruiz-Rubio, L.; Vilas, J.L. TiO2 Doped Electrospun Nanofibrous Membrane for Photocatalytic Water Treatment. Polymers 2019, 11, 747. [Google Scholar] [CrossRef] [PubMed]
- Daelemans, L.; Van der Heijden, S.; De Baere, I.; Rahier, H.; Van Paepegem, W.; De Clerck, K. Damage-Resistant Composites Using Electrospun Nanofibers: A Multiscale Analysis of the Toughening Mechanisms. ACS Appl. Mater. Interfaces 2016, 818, 11806–11818. [Google Scholar] [CrossRef] [PubMed]
- Seyhan, A.T.; Tanoglu, M.; Schulte, K. Mode I and mode II fracture toughness of E-glass non-crimp fabric/carbon nanotubes (CNT) modified polymer based composites. Eng. Fract. Mech. 2008, 75, 5151–5162. [Google Scholar] [CrossRef]
- Sager, R.J.; Klein, P.J.; Davis, D.C.; Davis, D.C.; Lagoudas, G.L.; Warren, G.L.; Sue, H.J. Interlaminar fracture toughness of woven fabric composite laminates with carbon nanotube/epoxy interleaf films. J. Appl. Polym. Sci. 2011, 121, 2394–2405. [Google Scholar] [CrossRef]
- Brugemann, V.P.; Sinke, J.; de Boer, H. Fracture Toughness Testing in FML. In Proceedings of the 25th Structural Dynamics Conference, Orlando, FL, USA, 19–22 February 2007; pp. 141–151. [Google Scholar]
- Wang, G.; Yu, D.; Kelkar, A.D.; Zhang, L. Electrospun nanofiber: Emerging reinforcing filler in polymer matrix composite materials. Prog. Polym. Sci. 2017, 75, 73–107. [Google Scholar] [CrossRef]
- Malakhov, S.N.; Belousov, S.L.; Shcherbina, M.A.; Meshchankina, M.Y.; Chvalun, S.N.; Shepelev, A.D. Effect of Low Molecular Additives on the Electrospinning of Nonwoven Materials from a Polyamide-6 Melt. Polym. Sci. Ser. A 2016, 58, 236–245. [Google Scholar] [CrossRef]
- Sinha-Ray, S.; Lee, M.W.; Sinha-Ray, S.; An, S.; Pourdeyhimi, B.; Yoon, S.S.; Yarin, A.L. Supersonic nanoblowing: A new ultra-stiff phase of nylon 6 in 20–50 nm confinement. J. Mater. Chem. C 2013, 1, 3491–3498. [Google Scholar] [CrossRef]

| Sample | σmax (MPa) | Δσmax (%) | δmax (%) |
|---|---|---|---|
| Reference [28] | 375.5 ± 33.2 | - | 2.2 ± 0.2 |
| 1veil PA6 [28] | 449.5 ± 10.8 | 19.7 | 2.1 ± 0.0 |
| 3 veils PA6 [28] | 415.4 ± 23.8 | 10.6 | 2.1 ± 0.2 |
| 1veil PA6 + 25 wt.% TiO2 | 468.1 ± 32.5 | 24.6 | 2.2 ± 0.2 |
| 3 veils PA6 + 25 wt.% TiO2 | 411.5 ± 25.4 | 9.6 | 2.1 ± 0.1 |
| Sample | Energy (J/m) | ΔE% | GIC (J/m2) | ΔGIC% |
|---|---|---|---|---|
| Reference [28] | 62.7 | - | 389 ± 12.8 | - |
| PA6 [28] | 68.1 | 8.6 | 466 ± 72.9 | 20.0 |
| PA6 + 25 wt.% TiO2 | 70.2 | 12.0 | 444 ± 46.1 | 14.0 |
© 2019 by the authors. Licensee MDPI, Basel, Switzerland. This article is an open access article distributed under the terms and conditions of the Creative Commons Attribution (CC BY) license (http://creativecommons.org/licenses/by/4.0/).
Share and Cite
Monteserín, C.; Blanco, M.; Murillo, N.; Pérez-Márquez, A.; Maudes, J.; Gayoso, J.; Laza, J.M.; Hernáez, E.; Aranzabe, E.; Vilas, J.L. Novel Antibacterial and Toughened Carbon-Fibre/Epoxy Composites by the Incorporation of TiO2 Nanoparticles Modified Electrospun Nanofibre Veils. Polymers 2019, 11, 1524. https://doi.org/10.3390/polym11091524
Monteserín C, Blanco M, Murillo N, Pérez-Márquez A, Maudes J, Gayoso J, Laza JM, Hernáez E, Aranzabe E, Vilas JL. Novel Antibacterial and Toughened Carbon-Fibre/Epoxy Composites by the Incorporation of TiO2 Nanoparticles Modified Electrospun Nanofibre Veils. Polymers. 2019; 11(9):1524. https://doi.org/10.3390/polym11091524
Chicago/Turabian StyleMonteserín, Cristina, Miren Blanco, Nieves Murillo, Ana Pérez-Márquez, Jon Maudes, Jorge Gayoso, Jose Manuel Laza, Estíbaliz Hernáez, Estíbaliz Aranzabe, and Jose Luis Vilas. 2019. "Novel Antibacterial and Toughened Carbon-Fibre/Epoxy Composites by the Incorporation of TiO2 Nanoparticles Modified Electrospun Nanofibre Veils" Polymers 11, no. 9: 1524. https://doi.org/10.3390/polym11091524
APA StyleMonteserín, C., Blanco, M., Murillo, N., Pérez-Márquez, A., Maudes, J., Gayoso, J., Laza, J. M., Hernáez, E., Aranzabe, E., & Vilas, J. L. (2019). Novel Antibacterial and Toughened Carbon-Fibre/Epoxy Composites by the Incorporation of TiO2 Nanoparticles Modified Electrospun Nanofibre Veils. Polymers, 11(9), 1524. https://doi.org/10.3390/polym11091524

